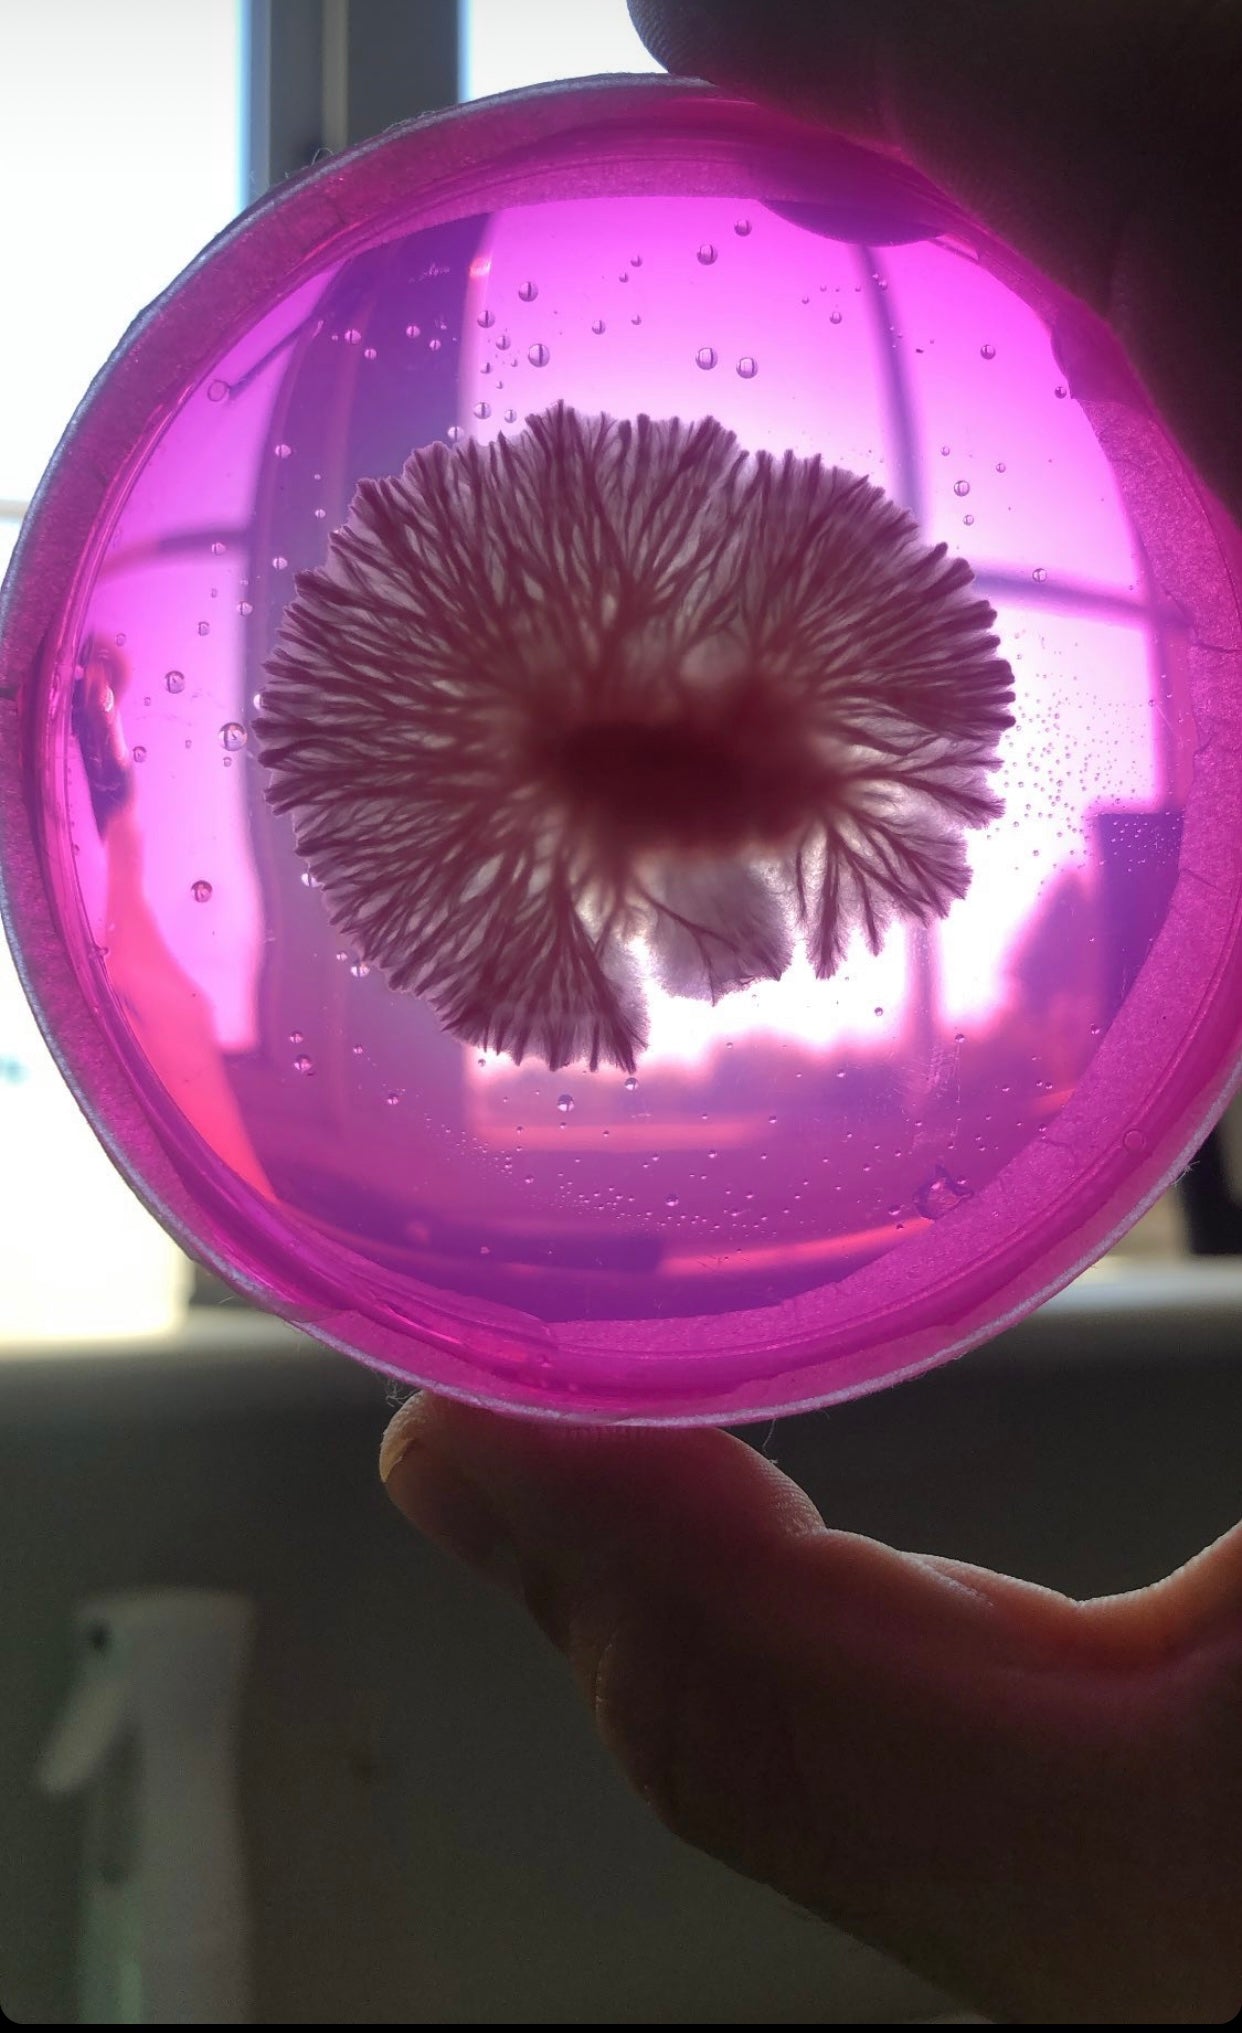

20 LME (Light Malt Extract) Agar Plates For Mushroom Cultivation
20 LME (Light Malt Extract) Agar Plates For Mushroom Cultivation
Earn [points_amount] when you buy this item.
Couldn't load pickup availability
THIS PRODUCT IS MADE TO ORDER CLICK HERE FOR LEAD / DELIVERY TIMES. THIS PRODUCT WILL NOT SHIP SAME DAY.
Skill Level: Beginner
Requirements: SAB/Flow Unit
Just like the 10 LME Agar Plates for Mushroom Cultivation but double the amount for NOT double the money - it’s like some mad kind of algae-based Christmas!
The gold standard of fungal culturing media! Light Malt Extract Agar, with customisations available, it’s up to you.
Made from 100% lab grade ingredients
If you’ve never used agar before, the short version is that it’s a bit like jelly (it’s a lot like jelly). Mix that together with some nutrients and you’ve got a medium for things to grow on. Mycelium loves it, so do various bacteria and other fungi. It’s also a handy 2D plane, so you can see exactly what’s happening, which allows you to remove the bits you like (put them on another plate and watch it get better and better), and get rid of the bits you don’t like. Science!
Once you’re happy with what you’ve selected, you can throw it into some liquid culture jars, or a bag of grain, and you know 100% that what you’ve got is as pure as the driven snow.
Agar is where you should be aiming for in your mushroom cultivation journey - if you want to grow literal canopies, clone massive mushrooms, or even clean up wild prints then this is how you do it. Learning how to use agar is one of the things Morpheus would’ve uploaded into Neo’s noggin, probably even before Kung-Fu and Bending About In Slo-Mo, it’s just that useful. Try it, learn it, and you’ll never look back.
Ideally you’d use a flow unit with your agar plates as this would guarantee that your plates will remain clear of any extra contaminants in your environment. You can make-do with a still air box, you’re just having a bit more of a gamble. We absolutely do not recommend using agar without one of these two methods as you’ll never know what’s floated onto your plate (although you can do whatever you want, it’ll work sometimes).
If you’d like this bundle a little cheaper, let us choose what colour you get.
Optional Extras:
- High Nutrient (30g/l of LME instead of 20g)
- High Nutrient + Soy Peptone
Available in the following colours:
- Rose Bengal (Bright Pink)
- Grass Green
- Ocean Blue
- Orange Red
Pre-poured in our 90mm triple vented plates, ready for use in an aseptic environment.
All of our agar products are covered by our 30 Day Returns Policy, same as our grain and substrate!